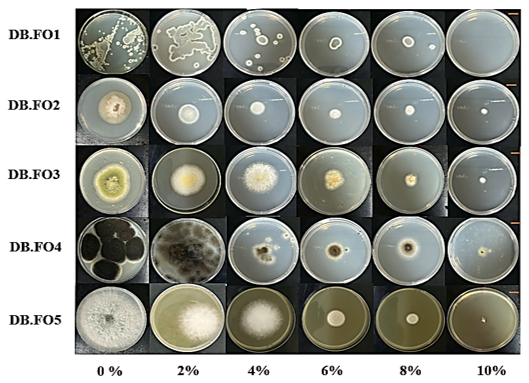

BIOLOGICAL CHARACTERISTICS OF SOME FILAMENTOUS FUNGAL STRAINS ISOLATED FROM RUBBER SURFACE AT THE DAM BAY MARINE CLIMATIC TESTING STATION, NHA TRANG
Department of Biotechnology, Joint Vietnam-Russia Tropical Science and Technology Research Center
Department of Biotechnology, Joint Vietnam-Russia Tropical Science and Technology Research Center
Phone: +84 982010336; Email: ngocaocuong2011@gmail.com
Main Article Content
Abstract
Fungal strains can readily colonize and thrive on the surface of rubber materials, particularly in tropical coastal or monsoon climates where high humidity, temperature, and salinity create favorable growth conditions. This study aimed to isolate and characterize filamentous fungal strains inhabiting the surface of rubber materials exposed to coastal climatic conditions at the Dam Bay Marine climatic testing station, Nha Trang, Vietnam. Three rubber samples were collected and assessed for microbial coverage following ASTM G21-15 (2015). High-resolution images were analyzed using ImageJ software, revealing fungal colonization levels ranging from 48.23 ± 3.7% to 68.23 ± 4.1%. Based on morphological characteristics, five isolates were obtained and classified into four genera: Fusarium, Aspergillus, Penicillium, and Nigrospora. All isolates exhibited optimal growth on PDA medium and demonstrated salt tolerance up to 4% (w/v) NaCl, indicating physiological adaptation to saline environments. Screening for extracellular laccase activity showed that DB.F05 was the only strain producing laccase, with a lysis zone diameter of 6 ± 0.5 mm. The identity of DB.F05 was confirmed by combining morphological observations with ITS region sequencing, showing 100% similarity to Nigrospora lacticolonia CGMCC 3.18123 (GenBank accession PV942108). These findings provide the first record of N. lacticolonia isolated from rubber surfaces in a tropical marine environment and reveal its potential enzymatic capability relevant to polymer modification or degradation. These are the results of a preliminary study to record the presence and biological characteristics of filamentous fungi on rubber surfaces in tropical coastal environments, providing a foundation for future studies on biodegradation mechanisms and antifungal preservation strategies.
Keywords
filamentous fungal strains, rubber materials, Nigrospora lacticolonia, fungal biodeterioration, isolation.
Article Details
- Highlights:
Five filamentous fungal strains belonging to four genera Penicillium, Fusarium, Aspergillus, and Nigrospora, were isolated from rubber surfaces exposed to coastal conditions in Dam Bay, Nha Trang, with surface coverage ranging from 48.23 ± 3.7% to 68.23 ± 4.1%.
All strains exhibited optimal growth on PDA medium and demonstrated salt tolerance up to 4% NaCl, highlighting their adaptability to marine environments.
Only Nigrospora lacticolonia DB.F05 showed extracellular laccase activity, forming a 6 ± 0.5 mm lysis zone, indicating its potential role in rubber biodegradation.
1. INTRODUCTION
Rubber is a versatile material widely used in industrial manufacturing, including sealing elements and technical parts. The primary component of natural rubber is cis-1,4-polyisoprene, but it also contains minor compounds such as carbohydrates, proteins, fatty acids, and phospholipids. These organic substances provide favorable substrates for microbial colonization, particularly by filamentous fungi [1].
In coastal environments like the Dam Bay testing station (Nha Trang), where high humidity, temperature, and salinity prevail, rubber materials are especially vulnerable to biodeterioration. The growth of filamentous fungi on rubber surfaces under such conditions can lead to discoloration, texture degradation, and reduced mechanical integrity. Moreover, salt-tolerant fungi possess specialized mechanisms to maintain osmotic balance and survive oxidative stress, enabling them to persist and slowly degrade materials in marine-influenced settings [2].
The composition of filamentous fungi involved in the biodeterioration of natural rubber surfaces is relatively diverse. In 2008, fungal strains belonging to the genera Fusarium, Penicillium, Trichoderma, Mucor, and others were isolated from natural rubber samples at a farm in northern Thailand [3].
The fungal hyphae tend to adhere to the surface and penetrate the material, producing extracellular polysaccharides (EPS) that aid in adhesion and biofilm formation. In particular, filamentous fungi capable of producing extracellular enzymes such as laccase and manganese peroxidase were responsible for the degradation of natural rubber source [4, 5]. These enzymes participate in substrate breakdown, particularly cis-1,4-polyisoprene, providing a carbon source for mold growth.
Although numerous studies have investigated the occurrence of filamentous fungi on rubber surfaces, knowledge of the biological characteristics and enzymatic activities of fungal strains colonizing rubber in tropical coastal regions such as the Dam Bay Marine Climatic Testing Station (Nha Trang) remains limited. This study aims to isolate filamentous fungi and provide fundamental data on their degradative effects on rubber surfaces, thereby contributing to the development of effective antifungal strategies for the preservation of rubber-based equipment in tropical and coastal environments.
2. RESEARCH MATERIALS AND METHODOLOGY
2.1. Research materials
03 rubber samples were collected at the Dam Bay Marine Climatic Testing Station, Nha Trang, Khanh Hoa in the dry, sunny conditions of August 2024. Rubber sheets were randomly selected, each 20 cm long and 15 cm wide. Samples were exposed to a uniform period of 3 months in a marine climate. The samples were stored in a cold box at about 4-10°C and brought to the Microbiology Laboratory - Department of Biotechnology, Joint Vietnam - Russia Tropical Science and Technology Research Center.
2.2. Research methodology
2.2.1. Evaluation of microbial coverage on the surface of materials
Rubber material samples infected with fungi were photographed using a Canon EOS 3000D camera. The fungal infection sites were observed and captured using a handheld DM WF120 microscope. Images were processed in ImageJ v.1.51 by converting to grayscale, adjusting the threshold to distinguish fungal hyphae from the background, and using the “Analyze particles” function to quantify the area covered [6]. The fungal coverage was calculated as a percentage of the surface area where fungal filaments had developed. The level of damage was determined according to ASTM G21-15 (2015) [7].
2.2.2. Sampling, isolation, and study of the biological characteristics of fungal strains on the surface of rubber materials
Sterilized cotton swabs were used to wipe the surface of rubber material samples infected with fungi in Dam Bay. Carefully, the swabs were placed into sterilized distilled water supplemented with 0.005% Tween 80, shaken at 200 rpm for 30 minutes. Then, 100 μL of the solution was spread evenly onto PDA agar plates supplemented with an antibiotic mixture (100 mg/L ampicillin; 100 mg/L tetracycline). Afterward, the agar plates were incubated at 30°C for 3-5 days. The fungal strains were purified through repeated subculturing on PDA agar medium [6].
The fungal strains were cultured on PDA agar medium with slanted coverslips at 28-30°C. After 72 hours, the coverslips were removed for the observation of the morphology of conidiophores and spores using a Zeiss Axiocam 503 Color Camera Unit optical microscope at 1000x magnification [8].
2.2.3. Evaluation of growth potential on different media
The fungal strains were cultured on three types of media: CZA, MEA, and PDA, supplemented with 100 mg/L ampicillin at a temperature of 30ºC for 3-5 days. Growth potential was determined based on the colony diameter of each fungal strain [6].
2.2.4. Evaluation of growth potential of filamentous fungal strains at different salt concentrations
The fungal strains were cultured on PDA medium supplemented with antibiotics (100 mg/L ampicillin; 100 mg/L tetracycline) at a temperature of 30°C for 7 days across various salt concentrations (0, 2, 4, 6, 8, 10%). Similarly, growth potential was determined based on the colony diameter of each fungal strain [2].
2.2.5. Evaluation of laccase enzyme synthesis ability
Laccase activity was determined using the agar well diffusion method. Briefly, agar plugs containing fungal strains were placed on substrate agar medium (0.05% guaiacol) and incubated for 24 h. Finally, enzyme activity was measured by the difference D - d, where D is the diameter of the clearing zone (mm), and d is the diameter of the agar plug (mm), using a stereomicroscope Nikon SMZ1270 at 6.3 × magnification. All measurements were performed in triplicate to ensure reproducibility [9].
2.2.6. Classification of fungal strains with activity using the ITS gene sequence amplification method
The total fungal DNA was extracted using the Fungi/Yeast DNA Extraction kit (Norgen, Canada). The ITS region was chosen due to its high variability among fungal species and its frequent use in fungal identification studies. The ITS1F/ITS4 primer pair is a widely accepted standard for amplifying this region. The sequence was amplified from the total DNA with the primer pair ITS1F (5'- CTT GGT CAT TTA GAG GAA GTA A - 3') and ITS4 (5' - TCC TCC GCT TAT TGA TAT GC - 3'). The thermal cycling profile for PCR using ITS primers includes an initial denaturation at 95°C for 3 minutes, followed by 30-35 cycles consisting of denaturation at 95°C for 30 seconds, primer annealing at 55°C for 30 seconds, and extension at 72°C for 60 seconds. The reaction ends with a final extension at 72°C for 5-10 minutes, and the products are then held at 4°C for storage. Besides, the sequences were processed using BioEdit software (ver. 6.0.7, USA) and phylogenetic trees were constructed using Mega X software (ver. 11) [6].
2.2.7. Data Processing
The data was processed on one-way ANOVA at a significance level of p < 0.05. The research data were statistically analyzed using Microsoft Excel 2019 (Microsoft Corporation, Redmond, WA, USA). All experiments were performed in triplicate.
3. RESULTS
3.1. The extent of fungal hyphae coverage on the rubber material surface
The surface of natural rubber sheets collected at the Dam Bay testing station, Nha Trang, Khanh Hoa, was studied to assess the level of fungal infection by assessing the coverage of mycelium on the material surface. All three collected samples exhibited the presence of filamentous fungi. Mycelium growing on the material surface is quite uniform, mainly dark blue or white, with widespread mycelium. The images of the material surface are described in Figure 1.

Figure 1. Surface of fungal-infected material sample: (a) photo of material sample, (b) fungal hyphae on sample surface taken at 20x magnification, (c) fungal hyphae analyzed using ImageJ image processing tool, (d) ratio of fungal hyphae area covering material surface.
The results of 20x magnification image analysis and evaluation by ImageJ software showed that both the front and back sides of the natural rubber sheet were observed to have extensive mycelial growth. There were differences in natural factors such as rainfall, light, and wind direction, leading to the difference between mycelial density on the front and back sides of the rubber sheet [10]. In which the back of the rubber sheet recorded a wide growth and development of filamentous fungi, averaging about 68.23 ± 4.1% of the surface area, while the filamentous fungi spread and covered 48.23 ± 3.7% of the front surface. According to ASTM G21-15 (2015), the front of the rubber sheet was covered by filamentous fungi at the level of damage No. 3 and the backside was at the level of damage No. 4 [7].
3.2. Morphological characteristics of isolated fungal strains
Five fungal strains were isolated from rubber materials and were named from DB.F01 to DB.F05. The isolated strains had significantly different colony morphology in terms of color and size. All strains developed mycelium and produced spores. The morphological characteristics of colonies on PDA medium, spore stalks, and spores of the isolated fungal strains under an optical microscope at 1000x magnification were shown in Figure 2.

Figure 2. Colony and spore morphology of pure fungal strains isolated from rubber materials at Dam Bay.
From the results of observing both the characteristics of the colonies and the sporophytes of the isolated strains, it is possible to classify the fungal strains into the genus. Based on the published results of the study on the biological morphology of molds, five mold strains were identified as belonging to 4 different genera: Penicillium, Aspergillus, Fusarium, and Nigrospora. The morphological characteristics of the 5 fungal strains were described in Table 1.
Table 1. Morphological characteristics of colonies and spores of isolated fungal strains


Among the five fungal strains isolated from the rubber sheet, DB.F01 exhibited the highest density on the front surface at 42.86%. The density of fungal strains on the front surface ranged from 5.71% to 42.86%. In contrast, DB.F05 appeared least frequently on the isolation plates, a trend also observed for strains isolated from the back surface of the rubber sheet, where densities ranged from 5.71% to 41.38% (Figure 3). In comparison with previous studies on the surface coverage density of filamentous fungi on composite materials, fungal strains belonging to the genus Penicillium exhibited the highest coverage, with values of 40.44% (P. corylophilum ELM.C2) and approximately 42% (Penicillium sp. DB.F01), respectively. The coverage density of Penicillium species was also the highest on both the front and back surfaces of rubber materials, as well as on all four sides of radar components made from composite materials [19].

Figure 3. Density of fungal strains isolated on the front and back surfaces of the rubber materials
3.3. Evaluation of growth ability on different media
After 5 days of culture on CZA, MEA, and PDA medium, the five filamentous fungal strains exhibited distinct morphology and sizes. The resulting images are described in Figure 4.

Figure 4. Growth characteristics and macroscopic morphology of fungi derived from natural rubber. Strains were inoculated in the center position on PDA, MEA and CZA plates. The inoculated plates were incubated at 30°C for 5 days. Standard scale = 10 mm
The colony size of the five filamentous fungal strains on PDA medium was significantly larger than on the other two media (p < 0.05, one-way ANOVA). The mean colony diameters of filamentous fungi on PDA medium was 21 ± 2 mm, 48 ± 2 mm, 52 ± 2 mm, 71 ± 3 mm, and 68 ± 1 mm for strains DB.F01 to DB.F05, respectively. The diameter of the fungal strains was approximately 1.2 to 2 times the diameter on the other media. Thus, PDA is a suitable medium for the growth conditions of the isolates from rubber sheets.
3.4. Evaluation of growth ability at different salt concentrations
The fungal strains, isolated from materials in a marine environment, exhibited growth variations on PDA medium due to the influence of NaCl. Different fungal strains showed different growth and responses to different concentrations of NaCl. Most of the fungal strains grew very well at concentrations of 0% and 2% (w/v) NaCl. Especially at 0% (w/v), the colony diameters of strains DB.F01 to DB.F05 were recorded as the largest, approximately 28 ± 3 mm, 41 ± 1 mm, 48 ± 1 mm, 64 ± 3 mm, and 77 ± 2 mm, respectively. The diameter gradually decreased as the NaCl concentration increased from 0% to 8% in most strains. At a concentration of 10% (w/v) NaCl, only 3 strains, DB.F02, DB.F03, and DB.F04, grew poorly, while the two strains, DB.F01 and DB.F05, did not grow.
Figure 5. Growth ability of isolates on PDA medium supplemented with 0, 2, 4, 6, 8, 10% (w/v) NaCl for 7 days at 30°C. Standard scale = 10 mm
3.5. The ability to produce extracellular enzymes of isolated fungal strains
Five fungal strains were evaluated for their ability to produce extracellular enzymes by measuring the diameter of the guaiacol degradation ring, which indicates laccase production. As shown in Figure 6, only one strain, DB.F05, exhibited laccase activity, with an enzyme ring diameter of approximately 6 ± 0.5 mm.

Figure 6. The inner circle shows the laccase biosynthesis ability of five filamentous fungi isolated on the surface of rubber materials.
3.6. Identification of active fungal strains
After DNA extraction and amplification using ITS primers, the electrophoresis result showed a clear band of approximately 550 bp. The band was sharp with no signs of nonspecific amplification or background noise, indicating that the sample is suitable for subsequent sequencing analysis for fungal identification (Figure 7a). After sequencing, the data were compared with the gene sequences in the GenBank database using the BLAST on NCBI (www.ncbi.nlm.nih.gov), from which a phylogenetic tree was constructed based on the Neighbor-joining method (Figure 7b).

Figure 7. (a) Electrophoresis result of the amplification product using ITS primers in 1% agarose, Marker: 500-10000bp (b) Phylogenetic tree showing the relationship between strain DB.F05 and reference strains in the NCBI database.
Based on the results of ITS region sequencing, the nucleotide sequence of the filamentous fungal strain DB.F05 has 100% similarity to the filamentous fungal strain Nigrospora lacticolonia CGMCC 3.18123 (NR_153471). Combining the characteristics of colony morphology, spore stalk and the results of self-amplification of the ITS gene region, DB.F05 was identified as Nigrospora lacticolonia DB.F05. This sequence was submitted to GenBank under accession number PV942108.
Table 3. Matrix showing the similarity of strain Nigrospora lacticolonia DB.F05 with reference strains in the NCBI database


4. DISCUSSION
The study highlights the significant fungal colonization on rubber materials in Dam Bay, with coverage reaching up to 68.23 ± 4.1%. The higher fungal density on the back side of the rubber sheet may be attributed to environmental factors such as reduced sunlight exposure and higher moisture retention, creating favorable conditions for fungal growth. The observed damage levels (No. 3 and No. 4) underscore the need for antifungal measures to preserve rubber materials in coastal environments. Besides, the coverage of filamentous fungi on the front side was equivalent to the composite material at the C35 Radar station in Son La, while the damage level on the backside was 1 level higher [19]. It is important to acknowledge that this study examined only three representative rubber samples, which may not fully capture the diversity and extent of filamentous fungal colonization across all rubber materials in the area. Nonetheless, the findings provide valuable baseline data indicating that the rubber surfaces at the Dam Bay testing station have been impacted by filamentous fungi.The isolation of five fungal strains from four genera (Penicillium, Fusarium, Aspergillus, and Nigrospora) aligns with previous studies reporting the prevalence of these genera on synthetic and rubber materials. Notably, Penicillium sp. (DB.F01) exhibited the highest coverage density (42.86%), consistent with findings by Lugauskas (2004) and Bok et al. (2019), who identified Penicillium as a dominant colonizer in moist conditions [20, 21]. In addition, researchers from the Joint Vietnam-Russia Tropical Science and Technology Research Center also isolated six fungal strains on composite materials collected at radar station C35 in Moc Chau (Son La) [19].
The superior growth of all strains on PDA medium suggests its nutritional suitability, likely due to the presence of potato-derived compounds that support fungal metabolism. The adaptability of these fungi to saline environments (up to 4% NaCl) reflects their ecological niche in coastal regions, where salt stress is a defining factor. The salt tolerance experiments revealed that while most strains tolerated low salinity, their growth was inhibited at higher concentrations (≥6% NaCl). Compared to previous studies on the growth ability of filamentous fungi under various NaCl conditions, the Aspergillus niger H4.7 strain showed the best growth and the highest phosphate solubilization in media without NaCl (0% w/v) and with 1% NaCl (w/v) [22]. Under salt conditions above 6% (w/v), the A. niger H4.7 strain did not grow. Similarly, the Penicillium funiculosum B1 strain exhibited the best growth in salt conditions ranging from 0% to 0.5% (w/v) [23]. From the above studies, filamentous fungal strains generally show the best growth in environments with NaCl concentrations ranging from 0-2% (w/v). However, for fungal strains isolated from rubber materials near marine environments, where the climatic conditions differ from normal, these strains can grow well in environments with NaCl concentrations up to 4% (w/v).
The laccase activity of Nigrospora lacticolonia DB.F05 is of particular interest, as this enzyme is implicated in the degradation of polyisoprene, the primary component of rubber. The observed degradation zone (6 mm) indicates moderate enzymatic activity, comparable to other rubber-degrading fungi such as Epicoccum sorghinum ELM.C6 and Camarosporium xanthochromaticum ELM.C5 [19].
This study provides the first evidence implicating N. lacticolonia in rubber degradation, particularly under marine tropical conditions - an environment characterized by high salinity, humidity, and temperature. Previous studies have predominantly focused on genera such as Penicillium, Aspergillus, Fusarium, and Alternaria as the main fungal agents responsible for rubber biodeterioration [4, 5]. Its extracellular laccase activity, capable of oxidizing cis-1,4-polyisoprene, suggests untapped biotechnological potential. Furthermore, recent taxonomic updates have shown that Nigrospora is an ecologically diverse genus associated mainly with endophytism or plant pathogenicity, not with polymer degradation [17, 18]. Therefore, this finding broadens the known diversity of rubber-degrading fungi and highlights Nigrospora as a novel candidate for biodegradation research and material preservation under extreme environments. These can be considered preliminary experiments and foundational data for more in-depth studies on microbial diversity in general, and filamentous fungi in particular, on rubber material surfaces. This also represents initial research efforts in assessing and managing mold contamination on such surfaces.
5. CONCLUSION
The study evaluated the coverage density of fungi on the surface of rubber materials at the Dam Bay testing station, Nha Trang, from 48.23 ± 3.7% to 68.23 ± 4.1%. Five strains of filamentous fungi with different colony and spore morphology belonging to the genera Fusarium, Aspergillus, Penicillium and Nigrospora were isolated. The isolated fungal strains all could grow well on PDA medium with diameters from 21 ± 2 mm to 71 ± 3 mm, and the best salt tolerance in the NaCl concentration range of 0% to 2% (w/v). The filamentous fungal strain DB.F05 was able to decompose the extracellular enzyme laccase with a decomposition circle diameter of 6 ± 0.5 mm. This filamentous fungal strain was identified as Nigrospora lacticolonia DB.F05 (PV942108) based on morphological analysis and ITS gene sequence amplification. This study provides initial data on the presence of filamentous fungi on rubber surfaces and some of their biological characteristics for adaptation and colonization of material surfaces..
Acknowledgments: This study was supported by funding from the UBPH project titled “Characteristics of microbial deterioration on materials and equipment, and development of protective measures under tropical climate conditions” (Project Code: T-1.3-2020-2024).
Author contributions: Nguyen Viet Cuong: Writing, original draft preparation; Nguyen Thi Kim Thanh: Review and editing; Nguyen Thi Hieu Thu: Conceptualization, Methodology; Ngo Cao Cuong: Conceptualization, Project administration.
Conflict of interest statement: The authors declare that there are no conflicts of interest related to this article.
References
2. L. Yovchevska et al., Response to salt stress of the halotolerant filamentous fungus Penicillium chrysogenum P13, Molecules, vol. 30, no. 6, pp. 1196, 2025. DOI: 10.3390/molecules30061196
3. S. Chanduaykit, Chemical control of filamentous fungi on para rubber (Hevea brasiliensis) sheets, Master of Science in Biotechnology Thesis. Price of Songkla University, Songkla Thailand, 2008.
4. F. Bosco et al., Biodegradation of unvulcanized natural rubber by microorganisms isolated from soil and rubber surface: A preliminary study, Bioremediation Journal, vol. 22, no. 1-2, pp. 43-52, 2018. DOI: 10.1080/10889868.2018.1476454
5. G. Nayanashree, B. Thippeswamy, Natural rubber degradation by laccase and manganese peroxidase enzymes of Penicillium chrysogenum, International Journal of Environmental Science and Technology, vol. 12, pp. 2665-2672, 2015. DOI: 10.1007/s13762-014-0636-6
6. C. C. Ngo et al., Identification of fungal community associated with deterioration of optical observation instruments of museums in Northern Vietnam, Applied Sciences, vol. 11, no. 12, pp. 5351, 2021. DOI: 10.3390/app11125351
7. G. ASTM, Standard practice for determining resistance of synthetic polymeric materials to fungi, American Society for Testing and Materials, 2015.
8. K. A. Seifert, W. Gams, The genera of Hyphomycetes–2011 update, Persoonia-Molecular Phylogeny and Evolution of Fungi, vol. 27, no. 1, pp. 119-129, 2011.
9. S. Vedashree, M. K. Sateesh, T. Lakshmeesha, S. S. Mohammed and A. Vedamurthy, Screening and assay of extracellular enzymes in Phomopsis azadirachtae causing die-back disease of neem, Journal of Agricultural Technology, vol. 9, no. 4, pp. 915-927, 2013.
10. D. Boniek, Q. S. Damaceno, C. S. de Abreu, I. de Castro Mendes, A. F. B. dos Santos and M. A. de Resende Stoianoff, Filamentous fungi associated with Brazilian stone samples: structure of the fungal community, diversity indexes, and ecological analysis, Mycological progress, vol. 18, pp. 565-576, 2019. DOI: 10.1007/s11557-019-01470-w
11. J. Smith, M. Lilly and R. Fox, The effect of agitation on the morphology and penicillin production of Penicillium chrysogenum, Biotechnology and bioengineering, vol. 35, no. 10, pp. 1011-1023, 1990. DOI: 10.1002/bit.260351009
12. C. Visagie et al., Identification and nomenclature of the genus Penicillium, Studies in mycology, vol. 78, no. 1, pp. 343-371, 2014. DOI: 10.1016/j.simyco.2014.09.001
13. A. C. d. S. Santos et al., Morphology, phylogeny, and sexual stage of Fusarium caatingaense and Fusarium pernambucanum, new species of the Fusarium incarnatum-equiseti species complex associated with insects in Brazil, Mycologia, vol. 111, no. 2, pp. 244-259, 2019. DOI: 10.1080/00275514.2019.1573047
14. P. E. Nelson, M. C. Dignani and E. J. Anaissie, Taxonomy, biology, and clinical aspects of Fusarium species, Clinical microbiology reviews, vol. 7, no. 4, pp. 479-504, 1994. DOI: 10.1128/cmr.7.4.479
15. K. Diba, P. Kordbacheh, S. H. Mirhendi, S. Rezaie, and M. Mahmoudi, Identification of Aspergillus species using morphological characteristics Pakistan, Journal of Medical Sciences, vol. 23, no. 6, pp.867-872, 2007.
16. D. M. Geiser, Sexual structures in Aspergillus: morphology, importance and genomics, Medical mycology, vol. 47, no. 1, pp. S21-S26, 2009.
17. Y. Hao et al., Nigrospora species associated with various hosts from Shandong Peninsula, China, Mycobiology, vol. 48, no. 3, pp. 169-183, 2020. DOI: 10.1080/12298093.2020.1761747
18. W. Lee et al., Diversity of Nigrospora (Xylariales, Apiosporaceae) species identified in Korean macroalgae including five unrecorded species, Mycobiology, vol. 51, no. 6, pp. 401-409, 2023. DOI: 10.1080/12298093.2023.2283272
19. D. M. Thuy et al., Biological characteristics of fungi isolated on composite materials at C35 radar station in Moc Chau, Son La, TNU Journal of Science and Technology, vol. 229, no. 09, pp. 250-257, 2024.
20. A. Lugauskas, I. Prosychevas, L. Levinskaitė and B. Jaskelevičius, Physical and chemical aspects of long‐term biodeterioration of some polymers and composites, Environmental Toxicology: An International Journal, vol. 19, no. 4, pp. 318-328, 2004. DOI: 10.1002/tox.20028
21. H. Ji, H. Kim, L. R. Beuchat and J. H. Ryu, Synergistic antimicrobial activities of essential oil vapours against Penicillium corylophilum on a laboratory medium and beef jerky, International journal of food microbiology, vol. 291, pp. 104-110, 2019. DOI: 10.1016/j.ijfoodmicro.2018.11.023
22. C. T. A. Thy, D. T. Y. Nhung and N. K. Nghia, Capacity in phosphorous solubilization and antagonism against the Fusarium solani fungal strain of the fungus Aspergillus niger H4.7 under the laboratory condition, CTU Journal of Science, vol. 57, no. 5, pp. 148-161, 2021.
23. T. T. P. Thu, N. K. Nghia, Isolation and selection of phosphate solubilizing fungi from rice soil applied with organic fertilizer and alternate wetting drying methodology of irrigation, CTU Journal of Science, vol. 54, no. 9, pp. 23-33, 2018.